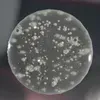
ノブリス・オーブ画像

バイオハザードレクイエムのアイテム一覧と入手方法です。バイオ9のアイテムの入手場所や効果についても掲載しています。バイオハザードレクイエムアイテムについて知りたい方はぜひ参考にしてください。
☆ストーリー攻略チャート/エンディング分岐
★最後の謎/最強武器/無限武器の入手方法
☆ファイル/ラクーン君/アンティークコイン
★時系列順に見るストーリーの歴史
☆評価レビュー

バイオハザードレクイエムのアイテム一覧と入手方法です。バイオ9のアイテムの入手場所や効果についても掲載しています。
目次
| アイテム | 入手方法/効果 | 種類 |
|---|---|---|
 ニッパー ニッパー |
入手方法 レンウッドホテルにある写真の裏側を調べると入手 効果 ワイヤーや電線などを切断するための工具。 |
重要 |
 天使の鍵 天使の鍵 |
入手方法 療養所の棚から入手 効果 見た目より重たく、冷たい鍵。刻まれた天使はこちらを見ていない。 |
重要 |
 オイルライター オイルライター |
入手方法 病室201の物置から入手 効果 装飾が施された金属製のオイル式ライター。暗闇を進む助けになる。 |
重要 |
 ドライバー ドライバー |
入手方法 スタッフルームの荷台を使って棚の上にある工具箱から入手 効果 錆びてブリップも黒ずんでいる。ネジを回すことはできそうだ。 |
重要 |
 ヒューズ ヒューズ |
入手方法 ドライバーを使って病室201の物置から入手 効果 ヒューズボックスに取り付けることで、電力を復旧できる。 |
重要 |
 管理棟のカードキー 管理棟のカードキー |
入手方法 詰所奥の部屋でイベント後入手 効果 血で汚れた金色のカードキー。療養所西館管理棟への扉が通行可能になる。 |
重要 |
 パントリーの鍵 パントリーの鍵 |
入手方法 療養所西棟1階のシェフを倒して入手 効果 「パントリー」と書かれたタグが付いた鍵。少しべとべとしている。 |
重要 |
 赤い宝石 赤い宝石 |
入手方法 一角獣の細工箱の中から入手 効果 年季の入った赤色の宝石。鮮血のように怪しく輝いている。 |
重要 |
 鉛筆 鉛筆 |
入手方法 理事長室の机で入手 効果 芯が滑らか芽の鉛筆。よく使い込まれている。 |
重要 |
 月のクォーツ 月のクォーツ |
入手方法 理事長室の謎解きボックスから入手 効果 水晶でできた立方体のオブジェ。月の装飾がされている。 |
重要 |
 病棟のカードキー 病棟のカードキー |
入手方法 療養所西棟1階プレイルームで入手 効果 無数の傷がついた銀色のカードキー。療養所東館病棟への扉が通行可能になる。 |
重要 |
 採血キット 採血キット |
入手方法 療養所の血液研究室、療養所で拾わなかった場合は、ARKの実験区画入口 効果 血液を採取できる研究用キット。集めた血液を変異させることでクラフト素材として使うことができる。 |
重要 |
 血液検体(変性) 血液検体(変性) |
入手方法 療養所東棟1階の血液研究室で入手 効果 ハンドガンの弾、破血アンプルがクラフト可能になる |
血液検体 |
 リストタグLv1 リストタグLv1 |
入手方法 療養所東棟2階の主任室前の廊下の西側に落ちている 効果 療養所のLv1までのセキュリティドアが通行可能になる |
重要 |
 血液検体(収束) 血液検体(収束) |
入手方法 療養所東棟1階の待合室にある物置。リストタグLv1で入れる 効果 回復アンプル、リボルバーの弾がクラフトできるようになる |
血液検体 |
 血液検体(可逆) 血液検体(可逆) |
入手方法 療養所東棟1階の血液研究室の東にある部屋 効果 ステロイド、スタビライザーをクラフトできるようになる |
血液検体 |
 血液検体(重合) 血液検体(重合) |
入手方法 難易度「インサニティ」限定。リストタグLv1を使って入れる待合室の物置にある 効果 RIPナイフ、ハンドガンの弾×30のクラフトが可能になる |
血液検体 |
 金属溶解液 金属溶解液 |
入手方法 カンファレンス室で入手 効果 ガラス瓶に入った強酸性の液体。特定の金属を瞬時に腐食させることができる。 |
重要 |
 太陽のクォーツ 太陽のクォーツ |
入手方法 療養所東棟2階の主任室のパズルを解く。パズルをするにはカンファレン室にある金属溶解液が必要 効果 水晶でできた立方体のオブジェ。太陽の装飾が施されている。 |
重要 |
 革張りの手帳 革張りの手帳 |
入手方法 太陽のパズルボックスのギミック解除で入手 効果 太陽のパズルボックスの中に保管されていた革手帳。 |
重要 |
 サイドパック サイドパック |
入手方法 療養所・プレイルーム(アンティークコイン3枚)、倉庫、地下、処理場、ARKBOWストレージ5 効果 身体に取り付けられる小さな収納パック。アイテムスロットの枠が2つ拡張される。 |
重要 |
 六角スパナ 六角スパナ |
入手方法 管理人室の机の上で入手 効果 六角のネジなどを回すことができる工具。少し油臭い。 |
重要 |
 臓器輸送ケース 臓器輸送ケース |
入手方法 療養所のガレージで入手 効果 臓器を低温で輸送できるケース。中身が入っているためか重たい |
重要 |
 人工肺 人工肺 |
入手方法 臓器輸送ケースのギミックを解除で入手 効果 機械式の臓器。人体に取り付けることで肺としての機能を果たす。 |
重要 |
 人工心臓 人工心臓 |
入手方法 六角スパナを使って冷凍庫内で入手 効果 機械式の臓器。人体に取り付けることで心臓としての機能を果たす。 |
重要 |
 リストタグLv2 リストタグLv2 |
入手方法 効果 療養所で利用される腕輪型の電子キー。Lv.2までのセキュリティドアが通行可能になる。 |
重要 |
 リストタグLv3 リストタグLv3 |
入手方法 療養所の警備長室で入手 効果 療養所で利用される腕輪型の電子キー。すべてのセキュリティドアが通行可能になる。 |
重要 |
 星のクォーツ 星のクォーツ |
入手方法 療養所地下クリア後に入手 効果 水晶でできた立方体のオブジェ。星の装飾が施されている。 |
重要 |
 ちぎれた手 ちぎれた手 |
入手方法 療養所エレベーターでのイベント後入手 効果 まだかすかに生温かい。 |
重要 |
 ジョイントプラグ ジョイントプラグ |
入手方法 療養所地下の係留所、懸吊室北の部屋、処理場で入手 効果 電気回路を接続するための部品。プラグソケットに取り付けることで電力を供給できる |
重要 |
 四角レンチ 四角レンチ |
入手方法 療養所地下のボイラー室の奥で入手 効果 四角形の窪みがある工具。ボルトの締め・外しに使用する |
重要 |
 フォークリフトの鍵 フォークリフトの鍵 |
入手方法 療養所地下の処理場の死体から入手 効果 フォークリフト用のイグニッションキー。長年の汚れで鈍くくすんでいる |
重要 |
 二重螺旋の模型 二重螺旋の模型 |
入手方法 療養所中庭のVIPルームでワインボトルのギミックを解いて入手 効果 DNAを彷彿とさせる二重螺旋状の模型。両側に突起物がついており、何か差し込めそうだ。 |
重要 |
 砂時計 砂時計 |
入手方法 療養所中庭の家でギミックを解くと入手 効果 ヴィンテージものの砂時計。よく手入れされている。 |
重要 |
 ヘリコプターの鍵 ヘリコプターの鍵 |
入手方法 療養所中庭の家地下で入手 効果 ヘリコプター用のイグニッションキー。ところどころ汚れてくすんでいる。 |
重要 |
 マリーの人形 マリーの人形 |
入手方法 最後の謎の一連のイベントを進めると、療養所中庭の地下の大抽出室に出現する 効果 エミリーを抱えた状態で、マリーの人形を持ったまま療養所の主任室のパズルで隠しコードを入力すると、最後の謎が解ける |
重要 |
 レバーハンドル レバーハンドル |
入手方法 備品保管庫の棚から入手 効果 回転装置を起動させるための手回しハンドル。 |
重要 |
 シダーブルックアパートメントの鍵 シダーブルックアパートメントの鍵 |
入手方法 ラクーン市街地のイーグルスター物流倉庫の3階で入手 効果 「中央キャンプ」から東側へいくための鍵付きの柵を開けられる |
重要 |
 分配器 分配器 |
入手方法 ラクーン市街地のイーグルスター物流倉庫の屋上にある黄色いボックス 効果 ラクーンシティのゲートを爆破するための起爆装置のパーツの一つ |
重要 |
 バッテリー バッテリー |
入手方法 ラクーン市街地、地下駐車場の北西の部屋と、下水施設2階にある部屋 効果 地下駐車場のシャッターを開けるためのバッテリー |
重要 |
 バルブハンドル バルブハンドル |
入手方法 ラクーン市街地の下水施設 効果 下水施設の壁を移動させるためのハンドル |
重要 |
 BSAAコンテナの鍵 BSAAコンテナの鍵 |
入手方法 シダーブルックアパートメント前でBSAA隊員のムービーを見た後に自動入手 効果 ラクーンシティ内の4つのBSAAコンテナを開けられる |
重要 |
 錆びたクランク 錆びたクランク |
入手方法 シダーブルックアパートメント内のBSAA隊員が出現するエリアの1階 効果 シダーブルックアパートメントの2階や地下駐車場の扉を開けるためのクランク |
重要 |
 壊れた信号解析器 壊れた信号解析器 |
入手方法 シダーブルックアパートメントの屋上の迫撃砲の横にある黄色いボックス 効果 起爆のための入力信号を監視・解析する役割を持つ部品。分配器と組み合わせて使う |
重要 |
 ポリタンク ポリタンク |
入手方法 ラクーン市街地北のガソリンスタンドでポリタンク入手後に給油する 効果 燃料を入れるための容器。ガソリンスタンドで燃料を入れるために使う |
重要 |
 燃料入りポリタンク 燃料入りポリタンク |
入手方法 ラクーン市街地北のガソリンスタンドでポリタンク入手後に給油する 効果 ガソリンスタンドで入手したポリタンクに燃料を入れたもの。発電機に入れるために使う |
重要 |
 リペアキット リペアキット |
入手方法 ラクーン市街地の中央キャンプにあるBSAAコンテナの中 効果 壊れた信号解析器を直すことができる |
重要 |
 継電器 継電器 |
入手方法 グリムストーンビルの屋上にある黄色いボックスで入手。ビルへ行くにはイーグルスター物流倉庫の4Fにあるガス欠の発電機に燃料を入れ、ジップラインに乗る 効果 ラクーンシティのゲートを爆破するための起爆装置の一つ。分配器と信号解析器と合わせて使用する |
重要 |
 油圧式ジャッキ 油圧式ジャッキ |
入手方法 警察署の図書館で拾う 効果 警察署内の錆びたシャッターを開けるのに使う |
重要 |
 ハッチの鍵 ハッチの鍵 |
入手方法 孤児院の院長室の壁にある。タンスを足場として使うと拾える 効果 孤児院の地下へ行くための鍵 |
重要 |
 火かき棒 火かき棒 |
入手方法 孤児院の霊安室の奥にある。棺を足場として使うと拾いに行ける 効果 孤児院の地下にあるハシゴを下ろすための道具 |
重要 |
 ブートキー(廃棄制御室) ブートキー(廃棄制御室) |
入手方法 ケミカルストレージで入手 効果 電源設備の起動キー。廃棄制御室の電力を復旧できる |
重要 |
 マグネットトークン マグネットトークン |
入手方法 ブートキー(廃棄制御室)を廃棄制御室で使用して壁から入手 効果 実験区画入口やクリーンルームの扉を開けられる |
重要 |
ノブリス・オーブ ノブリス・オーブ |
入手方法 ARK北西のオペレーションルームで入手。マグネットトークンが必要 効果 記録管理室に入るためのカギの一つ |
重要 |
 アニマ・オーブ アニマ・オーブ |
入手方法 ARK北東のクリーンルームで入手。マグネットトークンが必要 効果 記録管理室に入るためのカギの一つ |
重要 |
 ブートキー(B.O.W.ストレージ-11) ブートキー(B.O.W.ストレージ-11) |
入手方法 マネジメントルームで入手 効果 B.O.W.ストレージ-11のドアを開けるためのカギ |
重要 |
 グリーンハーブ グリーンハーブ |
入手方法 探索で入手 効果 体力をわずかに回復する緑色のハーブ。組み合わせることで回復量が大きく上がる。 |
回復 |
 回復アンプル 回復アンプル |
入手方法 クラフト、探索で入手 クラフト グリーンハーブ(濃)×1、感染者の血液×30【グレース】 グリーンハーブ×1、感染者の血液×60【グレース】 効果 応急治療用の携帯注射器。体力を完全回復する。 |
回復 |
 グリーンハーブ(濃) グリーンハーブ(濃) |
入手方法 クラフトから入手 クラフト グリーンハーブ×2【グレース】 グリーンハーブ×2【レオン】 効果 グリーンハーブを2つ組み合わせたもの。体力を中程度回復する。 |
回復 |
 グリーンハーブ(特濃) グリーンハーブ(特濃) |
入手方法 クラフトから入手 クラフト グリーンハーブ×3【グレース】 グリーンハーブ(濃)×1、グリーンハーブ×1【グレース】 グリーンハーブ×3【レオン】 グリーンハーブ(濃)×1、グリーンハーブ×1【レオン】 効果 グリーンハーブを3つ組み合わせたもの。体力を完全回復する。 |
回復 |
 スクラップ スクラップ |
入手方法 クラフト、探索で入手 クラフト 空き瓶×1、感染者の血液×80【グレース】 ハンティングナイフ×1【グレース】 クラフトナイフ×1【グレース】 効果 クラフト素材。組み合わせることで様々なアイテムを作成できる。 |
素材 |
 ステロイド ステロイド |
入手方法 療養所のプレイルームでアンティークコイン4枚と交換 クラフト 空のアンプル×1、感染者の血液×120【グレース】 効果 グレースの最大体力が上がる |
その他 |
 スタビライザー スタビライザー |
入手方法 療養所のプレイルームでアンティークコイン4枚と交換 クラフト 空のアンプル×1、感染者の血液×130【グレース】 効果 グレースの射撃の威力と安定性が上がる |
その他 |
 オーバーライドマニュアル オーバーライドマニュアル |
入手方法 プレイルームでアンティークコインを4枚使って入手 効果 採血キットのリミッター解除方法について記載したマニュアル。キットの容量を拡張することができる。 |
その他 |
 マスターライドマニュアル マスターライドマニュアル |
入手方法 スペシャルコンテンツで1000CPで購入 効果 採血キットの容量を永続的に+50拡張する |
その他 |
 空のアンプル 空のアンプル |
入手方法 療養所、療養所地下の牢屋の中で拾う 効果 スタビライザーやステロイドの作成素材 |
素材 |
 感染者の血液 感染者の血液 |
入手方法 探索、敵の死体から入手 効果 採血キットに注入してクラフトの素材として使う |
素材 |
 輸血バッグ 輸血バッグ |
入手方法 探索で入手 効果 感染者の血液が入った輸血バッグ。使用すると採血キットに補充される。採血キットからあふれた分は廃棄される。 |
その他 |
 破血アンプル 破血アンプル |
入手方法 クラフト、探索で入手 クラフト スクラップ×1、感染者の血液×60【グレース】 効果 感染者の血液細胞を崩壊させる特効薬。忍び寄ってステルスキルに使用可能。死体に打っても変異を抑制できる。 |
戦闘 |
 レアメタル レアメタル |
入手方法 探索で入手 効果 チタンやジルコニウムを含む希少金属の塊。感染者の血液と組み合わせることで、12.7×55mm弾を作成できる。 |
素材 |
 キーピック キーピック |
入手方法 探索で入手 効果 単純なカギを開けることができる道具。1度使うと無くなってしまう。 |
その他 |
 アンティークコイン アンティークコイン |
入手方法 探索で入手 効果 ゲーム筐体用の古びた金色の硬貨。プレイルームで景品と交換できる。 |
素材 |
 インクリボンケース インクリボンケース |
入手方法 探索 効果 インクリボンを作成するのに必要な素材 |
素材 |
 インクリボン インクリボン |
入手方法 探索 クラフト インクリボンケース×1、感染者の血液×40【グレース、難易度クラシック以上】 効果 難易度クラシック以上でタイプライターを使用する際に必要。使用すると無くなる |
その他 |
 インフィニティーインクリボン インフィニティーインクリボン |
入手方法 4時間以内にエルピスを解放してメインストーリーをクリア 効果 難易度クラシック以上でタイプライターを使用する際に必要。使用してもなくならないため無制限にセーブができる |
その他 |
 タクティカルトラッカーMod タクティカルトラッカーMod |
入手方法 ラクーン市街地の中央キャンプにあるサプライボックスの上で入手 効果 戦闘データを記録するための端末。サプライボックスでクレジットに交換可能 |
その他 |
 ハンドガンの弾 ハンドガンの弾 |
入手方法 拾う、サプライボックスから購入 クラフト スクラップ1×、感染者の血液×120【グレース、難易度インサニティ】 スクラップ×1、感染者の血液×40【グレース】 スクラップ×1、ガンパウダーS×1【レオン】 効果 自動装填に適したハンドガン用弾薬。反動が弱く弾道も安定し扱いやすいため広く使用されている。 |
弾薬 |
 ショットガンの弾 ショットガンの弾 |
入手方法 クラフト、サプライボックス、探索で見つかる クラフト スクラップ×1、ガンパウダーL×1【レオン】 効果 ショットガン用のバックショット弾・射撃時は小さな弾丸が放射状に散らばり接近戦において多大な威力を発揮する。 |
弾薬 |
 ライフルの弾 ライフルの弾 |
入手方法 クラフト、サプライボックス、探索で見つかる クラフト スクラップ×2、ガンパウダーL×1【レオン】 効果 貫通力の高いライフル狙撃用弾薬。直進性を重視した弾頭形状により弾道のブレが生じにくい。 |
弾薬 |
 マシンガンの弾 マシンガンの弾 |
入手方法 クラフト、サプライボックス、探索で見つかる クラフト スクラップ×2、ガンパウダーS×1【レオン】 効果 小型で携帯性に優れたマシンガン用弾薬。比較的反動が軽いため命中精度も高く、弾幕による制圧射撃も可能。 |
弾薬 |
 リボルバーの弾 リボルバーの弾 |
入手方法 パントリー、浄水場など クラフト レアメタル×1、感染者の血液×80【グレース】 効果 強力な大口径弾。その質量から生じる破壊力と衝撃で圧倒的なダメージを与える |
弾薬 |
 ガンパウダーS ガンパウダーS |
入手方法 探索で見つかる 効果 弾薬のクラフト素材。様々な弾薬を作成できる。 |
素材 |
 ガンパウダーL ガンパウダーL |
入手方法 探索で見つかる 効果 弾薬のクラフト素材。各種弾薬や衝撃手榴弾を作成できる。 |
素材 |
 TACトラッカー(コモン) TACトラッカー(コモン) |
入手方法 探索で見つかる 効果 戦闘データを記録するための端末。サプライボックスでクレジットに交換可能 |
その他 |
 TACトラッカー(レア) TACトラッカー(レア) |
入手方法 探索で見つかる 効果 戦闘データを記録するための端末。サプライボックスでクレジットに交換可能 |
その他 |
 TACトラッカー(レジェンド) TACトラッカー(レジェンド) |
入手方法 探索で見つかる 効果 戦闘データを記録するための端末。サプライボックスでクレジットに交換可能 |
その他 |
 ▶︎攻略TOPに戻る ▶︎攻略TOPに戻る |
|
 ストーリー ストーリー |
 謎解き 謎解き |
 キャラ キャラ |
 武器 武器 |
 チャーム チャーム |
 ボス・強敵 ボス・強敵 |
 アイテム アイテム |
- |
ゲームエイトをご利用いただきありがとうございます。
記事をより良くしていくために、「アイテム一覧と入手方法【バイオ9】」に関する間違いの指摘やご意見、感想などを募集しています。
不具合のご報告の際には、どのような状況でどのような症状が起きたかを可能な限り詳細にご記入ください。
この内容で送信しますか?
| 間違いの指摘・意見を送る |
|---|
アイテム一覧と入手方法【バイオ9】

Thank You

©CAPCOM CO., LTD. ALL RIGHTS RESERVED.
当サイトのコンテンツ内で使用しているゲーム画像の著作権その他の知的財産権は、当該ゲームの提供元に帰属しています。
当サイトはGame8編集部が独自に作成したコンテンツを提供しております。
当サイトが掲載しているデータ、画像等の無断使用・無断転載は固くお断りしております。

投稿したコメントにクイックアクセス!
コメント管理機能が実装されました!
無料会員登録いただくとすぐにご利用いただけます。

Game8.jpにネタバレ非表示機能が実装されました!
ネタバレを気にしない場合は、上部メニューより「ネタバレ非表示」機能をOFFにしてください。

お気に入りの記事にクイックアクセス!
お気に入り登録機能が実装されました!
無料会員登録いただくとすぐにご利用いただけます。
お気に入りがまだありません
気になる記事をお気に入りに追加してみましょう
